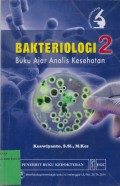
cover

Bakteriologi 1 Buku Ajar Analis Kesehatan
Buku ini ditujukan untuk melengkapi paket buku ajar bakteriologi bagi mahsiswa kesehatan terutama analis kesehatan laboratorium medik, yang didalamnya membahas karakteristik bakteriologi, dan secar…
- Edisi
- -
- ISBN/ISSN
- 978-979-044-608-3
- Deskripsi Fisik
- xii; 146 hlm; 24 cm
- Judul Seri
- -
- No. Panggil
- 616.92 KUS B

Bakteriologi 2 Buku aja Analis Kesehatan
Buku ini membahas tentang karakteristik bakteriologi, baik secara umum maupun khusus. Buku ini secara khusus membahas berbagai bakteri enterik dan selaput lendir yang lazim dijumpai dalam kehidupan
- Edisi
- -
- ISBN/ISSN
- 978-979-044-713-4
- Deskripsi Fisik
- x; 130 hlm; 24 cm
- Judul Seri
- -
- No. Panggil
- 616.92 KUS B

Bakteriologi 3 Buku Analis Kesehatan
Buku ini secara khusus membahas berbagai bakteri non-entrik/spesifik dan bakteri saluran kemih yang lazim di kehidupan sehari-hari
- Edisi
- -
- ISBN/ISSN
- 978-979-044-791-2
- Deskripsi Fisik
- xii; 134 hlm; 24 cm
- Judul Seri
- -
- No. Panggil
- 616.92 KUS B

Buku Ajar Virologi Untuk Analis Kesehatan
Buku ini membahas topik pengantar virologi, pengaruh & sistem imunpenyakit akibat virus, biakan 7 uji serologi virus, sebaran & diagnosis virus, pengetahuan bahan pemeriksaan laboratorium virologi,…
- Edisi
- -
- ISBN/ISSN
- 978-979-044-669-4
- Deskripsi Fisik
- xii; 188 hlm; 21 cm
- Judul Seri
- -
- No. Panggil
- 616.92 KUS B
Hasil Pencarian
Ditemukan 4 dari pencarian Anda melalui kata kunci: Pengarang : "Kuswiyanto"
Permintaan membutuhkan 0.00059 detik untuk selesai

Karya Umum
Karya Umum  Filsafat
Filsafat  Agama
Agama  Ilmu-ilmu Sosial
Ilmu-ilmu Sosial  Bahasa
Bahasa  Ilmu-ilmu Murni
Ilmu-ilmu Murni  Ilmu-ilmu Terapan
Ilmu-ilmu Terapan  Kesenian, Hiburan, dan Olahraga
Kesenian, Hiburan, dan Olahraga  Kesusastraan
Kesusastraan  Geografi dan Sejarah
Geografi dan Sejarah